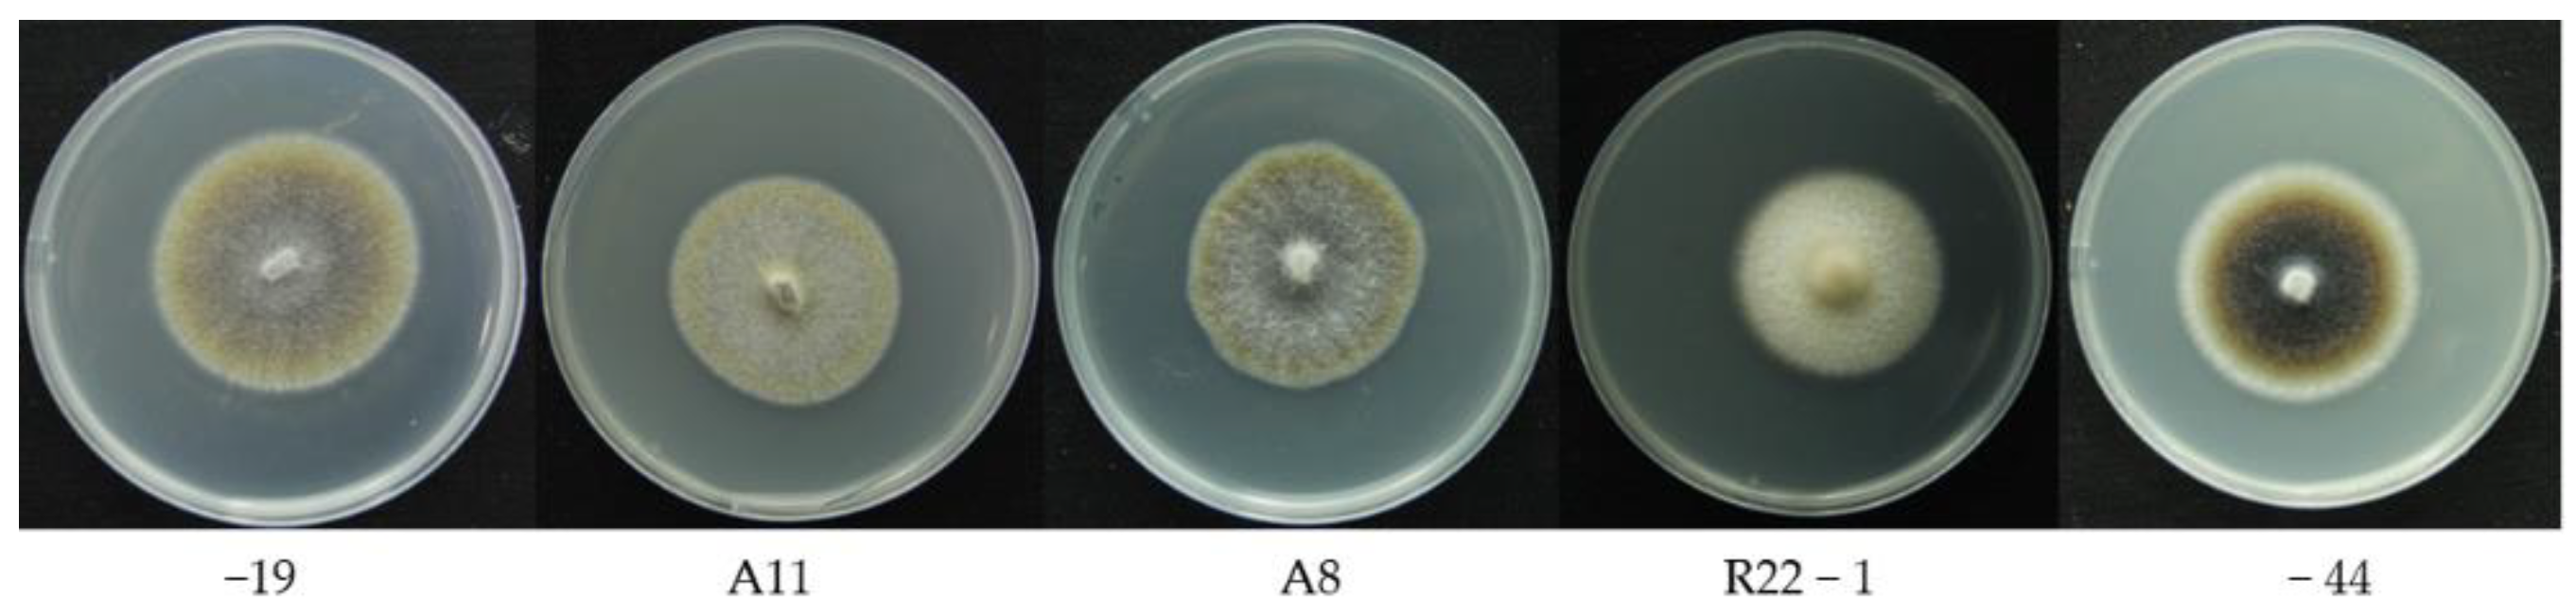
Jof 08 00978 g001

Fungi Classification in Various Growth Stages Using Shortwave Infrared (SWIR) Spectroscopy and Machine Learning
Abstract
:1. Introduction
2. Materials and Methods
2.1. Sample Preparation
2.2. SWIR Spectrum Acquisition
2.3. Model Calibration and Validation
2.4. Model Evaluation
3. Results
3.1. Fungi Classification in Different Growth Stages
3.2. Early Detection of Fungi in Different Species
3.3. Model Comparison
3.4. Model Evaluation for Fungi Classification
3.5. Model Evaluation for Early-Stage Detection
3.6. Importance Variable Selection
4. Discussion
5. Conclusions
Author Contributions
Funding
Institutional Review Board Statement
Informed Consent Statement
Data Availability Statement
Conflicts of Interest
References
- Rodriguez, R.; White, J., Jr.; Arnold, A.E.; Redman, A.R.A. Fungal endophytes: Diversity and functional roles. New Phytol. 2009, 182, 314–330. [Google Scholar] [CrossRef] [PubMed]
- Peay, K.G.; Kennedy, P.G.; Talbot, J.M. Dimensions of biodiversity in the Earth mycobiome. Nat. Rev. Microbiol. 2016, 14, 434–447. [Google Scholar] [CrossRef] [PubMed]
- Qin, Y.; Pan, X.; Kubicek, C.; Druzhinina, I.; Chenthamara, K.; Labbé, J.; Yuan, Z. Diverse plant-associated pleosporalean fungi from saline areas: Ecological tolerance and nitrogen-status dependent effects on plant growth. Front. Microbiol. 2017, 8, 158. [Google Scholar] [CrossRef] [PubMed]
- Gostinčar, C.; Grube, M.; De Hoog, S.; Zalar, P.; Gunde-Cimerman, N. Extremotolerance in fungi: Evolution on the edge. FEMS Microbiol. Ecol. 2009, 71, 2–11. [Google Scholar] [CrossRef] [PubMed]
- Yuan, Z.; Druzhinina, I.S.; Labbé, J.; Redman, R.; Qin, Y.; Rodriguez, R.; Zhang, C.; Tuskan, G.A.; Lin, F. Specialized microbiome of a halophyte and its role in helping non-host plants to withstand salinity. Sci. Rep. 2016, 6, 32467. [Google Scholar] [CrossRef]
- Williams, P.J.; Geladi, P.; Britz, T.J.; Manley, M. Growth characteristics of three Fusarium species evaluated by near-infrared hyperspectral imaging and multivariate image analysis. Appl. Microbiol. Biotechnol. 2012, 96, 803–813. [Google Scholar] [CrossRef]
- Yao, H.; Hruska, Z.; Kincaid, R.; Brown, R.L.; Cleveland, T.E. Differentiation of toxigenic fungi using hyperspectral imagery. Sens. Instrum. Food Qual. Saf. 2008, 2, 215–224. [Google Scholar] [CrossRef]
- Mohd Hilmi Tan, M.I.S.; Jamlos, M.F.; Omar, A.F.; Dzaharudin, F.; Chalermwisutkul, S.; Akkaraekthalin, P. Ganoderma boninense disease detection by near-infrared spectroscopy classification: A review. Sensors 2021, 21, 3052. [Google Scholar] [CrossRef]
- Miao, X.; Miao, Y.; Tao, S.; Liu, D.; Chen, Z.; Wang, J.; Huang, W.; Yu, Y. Classification of rice based on storage time by using near infrared spectroscopy and chemometric methods. Microchem. J. 2021, 171, 106841. [Google Scholar] [CrossRef]
- Zhang, Y.; Luan, Q.; Jiang, J.; Li, Y. Prediction and utilization of malondialdehyde in exotic pine under drought stress using near-infrared spectroscopy. Front. Plant Sci. 2021, 12, 735275. [Google Scholar] [CrossRef]
- Li, Y.; Sun, H.; Tomasetto, F.; Jiang, J.; Luan, Q. Spectrometric Prediction of Nitrogen Content in Different Tissues of Slash Pine Trees. Plant Phenomics 2022, 2022, 9892728. [Google Scholar] [CrossRef] [PubMed]
- Lu, Y.; Wang, W.; Huang, M.; Ni, X.; Chu, X.; Li, C. Evaluation and classification of five cereal fungi on culture medium using Visible/Near-Infrared (Vis/NIR) hyperspectral imaging. Infrared Phys. Technol. 2020, 105, 103206. [Google Scholar] [CrossRef]
- Sun, Y.; Gu, X.; Wang, Z.; Huang, Y.; Wei, Y.; Zhang, M.; Tu, K.; Pan, L. Growth simulation and discrimination of Botrytis Cinerea, Rhizopus Stolonifer and Colletotrichum Acutatum using hyperspectral reflectance imaging. PLoS ONE 2015, 10, e0143400. [Google Scholar] [CrossRef]
- Vapnik, V. The Nature of statistical Learning Theory; Springer Science & Business Media: Berlin/Heidelberg, Germany, 1999. [Google Scholar]
- Breiman, L. Random forests. Mach. Learn. 2001, 45, 5–32. [Google Scholar] [CrossRef]
- Atkinson, P.M.; Tatnall, A.R. Introduction neural networks in remote sensing. Int. J. Remote Sens. 1997, 18, 699–709. [Google Scholar] [CrossRef]
- Pérez-Cruz, F.; Artés-Rodríguez, A. Puncturing multi-class support vector machines. In Proceedings of the International Conference on Artificial Neural Networks, Madrid, Spain, 28–30 August 2002; pp. 751–756. [Google Scholar]
- Raghavendra, N.S.; Deka, P.C. Support vector machine applications in the field of hydrology: A review. Appl. Soft Comput. 2014, 19, 372–386. [Google Scholar] [CrossRef]
- Biau, G. Analysis of a random forests model. J. Mach. Learn. Res. 2012, 13, 1063–1095. [Google Scholar]
- Cutler, D.R.; Edwards, T.C., Jr.; Beard, K.H.; Cutler, A.; Hess, K.T.; Gibson, J.; Lawler, J.J. Random forests for classification in ecology. Ecology 2007, 88, 2783–2792. [Google Scholar] [CrossRef]
- Ok, A.O.; Akar, O.; Gungor, O. Evaluation of random forest method for agricultural crop classification. Eur. J. Remote Sens. 2012, 45, 421–432. [Google Scholar] [CrossRef]
- Wang, C.; Zhang, Y.; Han, S. Its2vec: Fungal species identification using sequence embedding and random forest classification. BioMed Res. Int. 2020, 2020, 2468789. [Google Scholar] [CrossRef]
- Chauhan, M.D. Detection of maize disease using random forest classification algorithm. Turk. J. Comput. Math. Educ. (TURCOMAT) 2021, 12, 715–720. [Google Scholar]
- Delashmit, W.H.; Manry, M.T. Recent developments in multilayer perceptron neural networks. In Proceedings of the Seventh Annual Memphis Area Engineering and Science Conference, Memphis, TN, USA, 11 May 2005. [Google Scholar]
- Heidari, A.A.; Faris, H.; Mirjalili, S.; Aljarah, I.; Mafarja, M. Ant Lion Optimizer: Theory, Literature Review, and Application in Multi-layer Perceptron Neural Networks; Springer: Cham, Switzerland, 2020; pp. 23–46. [Google Scholar]
- Salehi, M.; Farhadi, S.; Moieni, A.; Safaie, N.; Ahmadi, H. Mathematical modeling of growth and paclitaxel biosynthesis in Corylus avellana cell culture responding to fungal elicitors using multilayer perceptron-genetic algorithm. Front. Plant Sci. 2020, 11, 1148. [Google Scholar] [CrossRef] [PubMed]
- Ramchoun, H.; Ghanou, Y.; Ettaouil, M.; Janati Idrissi, M.A. Multilayer Perceptron: Architecture Optimization and Training. 2016. Available online: https://reunir.unir.net/handle/123456789/11569 (accessed on 12 August 2022).
- Barnes, R.; Dhanoa, M.S.; Lister, S.J. Standard normal variate transformation and de-trending of near-infrared diffuse reflectance spectra. Appl. Spectrosc. 1989, 43, 772–777. [Google Scholar] [CrossRef]
- Cameron, D.G.; Moffatt, D.J. A generalized approach to derivative spectroscopy. Appl. Spectrosc. 1987, 41, 539–544. [Google Scholar] [CrossRef]
- Yang, S.-Y.; Han, Y.; Chang, Y.-S.; Park, J.-H.; Park, Y.; Chung, H.; Yeo, H. Classification of the hot air heat treatment degree of larch wood using a multivariate analysis of near-infrared spectroscopy. J. Wood Sci. 2018, 64, 220–225. [Google Scholar] [CrossRef]
- Babatunde, O.H.; Armstrong, L.; Leng, J.; Diepeveen, D. A Genetic Algorithm-Based Feature Selection. Br. J. Math. Comput. Sci. 2014, 4, 889–905. [Google Scholar]
- Li, H.-D.; Zeng, M.-M.; Tan, B.-B.; Liang, Y.-Z.; Xu, Q.-S.; Cao, D.-S. Recipe for revealing informative metabolites based on model population analysis. Metabolomics 2010, 6, 353–361. [Google Scholar] [CrossRef]
- Frank, I.E. Intermediate least squares regression method. Chemom. Intell. Lab. Syst. 1987, 1, 233–242. [Google Scholar] [CrossRef]
- Tran, T.N.; Afanador, N.L.; Buydens, L.M.; Blanchet, L. Interpretation of variable importance in partial least squares with significance multivariate correlation (sMC). Chemom. Intell. Lab. Syst. 2014, 138, 153–160. [Google Scholar] [CrossRef]
- Pannell, D.J. Sensitivity analysis: Strategies, methods, concepts, examples. Agric. Econ. 1997, 16, 139–152. [Google Scholar] [CrossRef]
- Mehmood, T.; Liland, K.H.; Snipen, L.; Sæbø, S. A review of variable selection methods in partial least squares regression. Chemom. Intell. Lab. Syst. 2012, 118, 62–69. [Google Scholar] [CrossRef]
- Guzmán, E.; Baeten, V.; Pierna, J.A.F.; García-Mesa, J.A. Application of low-resolution Raman spectroscopy for the analysis of oxidized olive oil. Food Control. 2011, 22, 2036–2040. [Google Scholar] [CrossRef]
- Li, Y.; Sharma, M.; Altaner, C.; Cookson, L.J. An approach to quantify natural durability of Eucalyptus bosistoana by near infrared spectroscopy for genetic selection. Ind. Crops Prod. 2020, 154, 112676. [Google Scholar] [CrossRef]
- Plischke, E. An effective algorithm for computing global sensitivity indices (EASI). Reliab. Eng. Syst. Saf. 2010, 95, 354–360. [Google Scholar] [CrossRef]
- Zouhri, W.; Homri, L.; Dantan, J.-Y. Handling the impact of feature uncertainties on SVM: A robust approach based on Sobol sensitivity analysis. Expert Syst. Appl. 2022, 189, 115691. [Google Scholar] [CrossRef]
- Şandru, E.-D.; David, E.; Kovacs, I.; Buzo, A.; Burileanu, C.; Pelz, G. Modeling the Dependency of Analog Circuit Performance Parameters on Manufacturing Process Variations With Applications in Sensitivity Analysis and Yield Prediction. IEEE Trans. Comput.-Aided Des. Integr. Circuits Syst. 2021, 41, 129–142. [Google Scholar] [CrossRef]
- Jiang, S.-F.; Fu, D.-B.; Wu, S.-Y. Structural Reliability Assessment by Integrating Sensitivity Analysis and Support Vector Machine. Math. Probl. Eng. 2014, 2014, 586191. [Google Scholar] [CrossRef]
- Kimuli, D.; Wang, W.; Jiang, H.; Zhao, X.; Chu, X.; Yang, Y.; Jia, B. Evaluation of growth characteristics of a mixed culture of toxigenic fungi by Visible/Near-infrared hyperspectral imaging. In Proceedings of the 2018 ASABE Annual International Meeting, Detroit, MI, USA, 29 July–1 August 2018; p. 1. [Google Scholar]
- Herrmann, I.; Karnieli, A.; Bonfil, D.; Cohen, Y.; Alchanatis, V. SWIR-based spectral indices for assessing nitrogen content in potato fields. Int. J. Remote Sens. 2010, 31, 5127–5143. [Google Scholar] [CrossRef]
- Hansen, M.P.; Malchow, D.S. Overview of SWIR detectors, cameras, and applications. In Proceedings of the Thermosense Xxx, Orlando, FL, USA, 17 March 2008; pp. 94–104. [Google Scholar]
- Yuan, Z.; Druzhinina, I.S.; Wang, X.; Zhang, X.; Peng, L.; Labbé, J. Insight into a highly polymorphic endophyte isolated from the roots of the halophytic seepweed Suaeda salsa: Laburnicola rhizohalophila sp. nov. (Didymosphaeriaceae, Pleosporales). Fungal Biol. 2020, 124, 327–337. [Google Scholar] [CrossRef]
- Marx, D.H. The Influence of ectotrophic mycorrhizal fungi on the resistance of pine roots to pathogenic infections. V. Resistance of mycorrhizae to infection by vegetative mycelium of Phytophthora cinnamomi. Phytopathology 1970, 60, 1472–1473. [Google Scholar] [CrossRef]
- Alchanatis, V.; Schmilovitch, Z.; Meron, M.J.P.A. In-field assessment of single leaf nitrogen status by spectral reflectance measurements. Precis. Agric. 2005, 6, 25–39. [Google Scholar] [CrossRef]
- Cortez, P.; Embrechts, M.J. Using sensitivity analysis and visualization techniques to open black box data mining models. Inf. Sci. 2013, 225, 1–17. [Google Scholar] [CrossRef]
- Li, Y.; Al-Sarayreh, M.; Irie, K.; Hackell, D.; Bourdot, G.; Reis, M.M.; Ghamkhar, K. Identification of weeds based on hyperspectral imaging and machine learning. Front. Plant Sci. 2021, 11, 611622. [Google Scholar] [CrossRef]
- Markoulidakis, I.; Rallis, I.; Georgoulas, I.; Kopsiaftis, G.; Doulamis, A.; Doulamis, N. Multiclass Confusion Matrix Reduction Method and Its Application on Net Promoter Score Classification Problem. Technologies 2021, 9, 81. [Google Scholar] [CrossRef]
- Team, R.C. R: A Language and Environment for Statistical Computing. Available online: https://www.r-project.org (accessed on 1 May 2022).
- Allaire, J. Integrated Development Environment; RStudio: Boston, MA, USA, 2012; Volume 770, p. 394. [Google Scholar]
- Kuhn, M.; Caret: Classification and Regression Training. Astrophysics Source Code Library. Available online: https://ui.adsabs.harvard.edu/abs/2015ascl.soft05003K (accessed on 7 May 2022).
- Stevens, A.; Ramirez–Lopez, L. An Introduction to the Prospectr Package. 2014. Available online: https://cran.r-project.org/web/packages/prospectr/vignettes/prospectr-intro.pdf (accessed on 1 May 2022).
- Cortez, P.; Rminer: Data Mining Classification and Regression Methods. R Package Version 1.4.2. Available online: https://cran.r-project.org/web/packages/rminer/rminer.pdf (accessed on 7 May 2022).
- Wickham, H. Ggplot2: Elegant Graphics for Data Analysis; Springer: Berlin/Heidelberg, Germany, 2016. [Google Scholar]
- Williams, P.J.; Geladi, P.; Britz, T.J.; Manley, M. Near-infrared (NIR) hyperspectral imaging and multivariate image analysis to study growth characteristics and differences between species and strains of members of the genus Fusarium. Anal. Bioanal. Chem. 2012, 404, 1759–1769. [Google Scholar] [CrossRef] [PubMed]
- Wu, Y.; Yun, Y.; Chen, J.; Liu, D. Discrimination of Waxy Wheats Using Near-Infrared Hyperspectral Spectroscopy. Food Anal. Methods 2021, 14, 1704–1713. [Google Scholar] [CrossRef]
- Xu, L.; Fu, X.-S.; Cai, C.-B.; She, Y.-B. The Feasibility of Using Near Infrared Spectroscopy for Rapid Discrimination of Aged Shiitake Mushroom (Lentinula edodes) after Long-Term Storage. J. Chem. 2015, 2015, 692983. [Google Scholar] [CrossRef]
- Yao, S.; Li, J.; Li, T.; Liu, H.; Wang, Y. Discrimination of Boletaceae mushrooms based on data fusion of FT-IR and ICP–AES combined with SVM. Int. J. Food Prop. 2018, 21, 255–266. [Google Scholar] [CrossRef]
- Wu, H.; Song, Z.; Niu, X.; Liu, J.; Jiang, J.; Li, Y. Classification of Toona sinensis Young Leaves Using Machine Learning and UAV-Borne Hyperspectral Imagery. Front. Plant Sci. 2022, 13, 940327. [Google Scholar] [CrossRef]
- Castro, W.; Oblitas, J.; Maicelo, J.; Avila-George, H. Evaluation of expert systems techniques for classifying different stages of coffee rust infection in hyperspectral images. Int. J. Comput. Intell. Syst. 2018, 11, 86. [Google Scholar] [CrossRef]
- Wakholi, C.; Kandpal, L.M.; Lee, H.; Bae, H.; Park, E.; Kim, M.S.; Mo, C.; Lee, W.-H.; Cho, B.-K. Rapid assessment of corn seed viability using short wave infrared line-scan hyperspectral imaging and chemometrics. Sens. Actuators B Chem. 2018, 255, 498–507. [Google Scholar] [CrossRef]
- Kumar, L.; Schmidt, K.; Dury, S.; Skidmore, A. Imaging Spectrometry and Vegetation Science. In Imaging Spectrometry: Basic Principles and Prospective Applications; Meer, F.D.V.D., Jong, S.M.D., Eds.; Springer: Dordrecht, The Netherlands, 2001; pp. 111–155. [Google Scholar]
- Schwanninger, M.; Rodrigues, J.C.; Fackler, K. A Review of Band Assignments in near Infrared Spectra of Wood and Wood Components. J. Near Infrared Spectrosc. 2011, 19, 287–308. [Google Scholar] [CrossRef]
- Curran, P.J. Remote sensing of foliar chemistry. Remote Sens. Environ. 1989, 30, 271–278. [Google Scholar] [CrossRef]

| Model Types | Generic Model | OA | |
|---|---|---|---|
| Cal | Val | ||
| Fungi classification | SVM | 0.92 | 0.76 |
| RF | 0.91 | 0.75 | |
| MLP | 0.91 | 0.77 | |
| Early detection | SVM | 0.99 | 0.92 |
| RF | 0.99 | 0.92 | |
| MLP | 0.98 | 0.91 | |
Publisher’s Note: MDPI stays neutral with regard to jurisdictional claims in published maps and institutional affiliations. |
© 2022 by the authors. Licensee MDPI, Basel, Switzerland. This article is an open access article distributed under the terms and conditions of the Creative Commons Attribution (CC BY) license (https://creativecommons.org/licenses/by/4.0/).
Share and Cite
Liu, Z.; Li, Y. Fungi Classification in Various Growth Stages Using Shortwave Infrared (SWIR) Spectroscopy and Machine Learning. J. Fungi 2022, 8, 978. https://doi.org/10.3390/jof8090978
Liu Z, Li Y. Fungi Classification in Various Growth Stages Using Shortwave Infrared (SWIR) Spectroscopy and Machine Learning. Journal of Fungi. 2022; 8(9):978. https://doi.org/10.3390/jof8090978
Chicago/Turabian StyleLiu, Zhuo, and Yanjie Li. 2022. "Fungi Classification in Various Growth Stages Using Shortwave Infrared (SWIR) Spectroscopy and Machine Learning" Journal of Fungi 8, no. 9: 978. https://doi.org/10.3390/jof8090978
APA StyleLiu, Z., & Li, Y. (2022). Fungi Classification in Various Growth Stages Using Shortwave Infrared (SWIR) Spectroscopy and Machine Learning. Journal of Fungi, 8(9), 978. https://doi.org/10.3390/jof8090978






